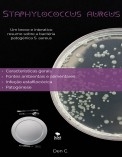

São os cookies mais básicos. Permitem ao utilizador navegar numa página web, plataforma ou aplicação e utilizar as diferentes opções ou serviços nela existentes, como, por exemplo, controlar o tráfego e a comunicação de dados, identificar a sessão, aceder a partes de acesso restrito, recordar o elementos que compõem um pedido, realizam o processo de compra de um pedido, fazem um pedido de inscrição ou participação em um evento, utilizam elementos de segurança durante a navegação, armazenam conteúdo para divulgação de vídeos ou som. Esses cookies são necessários para o bom funcionamento do site e não podem ser desativados.
| Cookie |
Modelo |
Duração |
Descrição |
| sessid |
0 |
12 meses |
Permite que a plataforma da Bubok armazene informações relacionadas à sessão aberta do usuário |
| mostrarsabiasqueids |
0 |
12 meses |
Permite que a plataforma da Bubok controlar as informações importantes para mostrar a cada utilizador, de forma a melhorar a experiência dentro do site |
| ultimoslibros |
0 |
5 dias |
Permite à plataforma da Bubok controlar informações relevantes para os livros mais recentes vendidos dentro da livraria Bubok |
| popup_contacto_bubok |
0 |
24 meses |
Permite que a plataforma da Bubok controle a visibilidade do formulário de contato flutuante, a fim de melhorar a experiência do usuário dentro do site |